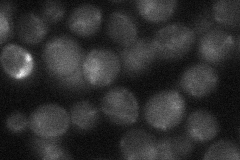
YLR098C
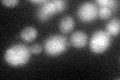
YLR098C
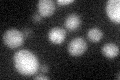
YLR098C

View description
DNA binding transcriptional activator, mediates serine/threonine activation of the catabolic L-serine (L-threonine) deaminase (CHA1); Zinc-finger protein with Zn[2]-Cys[6] fungal-type binuclear cluster domain
Localization:
Intensity:
Fold change:
Significance:
-
C’ GFP library in SD

nucleus18.53 -
N' NOP1pr-GFP in SD

punctate,nucleus43.4728 -
N' TEF2pr-mCherry in SD

punctate,nucleus11.6229 -
N' NATIVEpr-GFP in SD
punctate23.3525 -
N' TEF2pr-VC and Cyto-VN in SD

below threshold25.809 -
C’ GFP library in SD+DTT
nucleus19.581.05No -
C’ GFP library in SD+H2O2
nucleus21.161.14No -
C’ GFP library in Starvation Media

nucleus17.360.93No -
C’ GFP library on the background of Pup2-DaMP

nucleus -
C’ GFP library on the background of CCT mutant

nucleus19.07851.0292No
